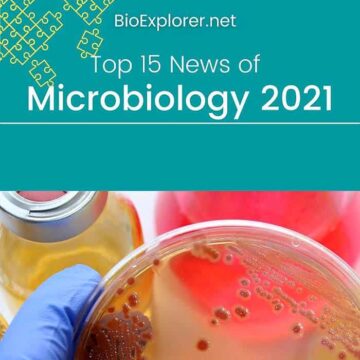
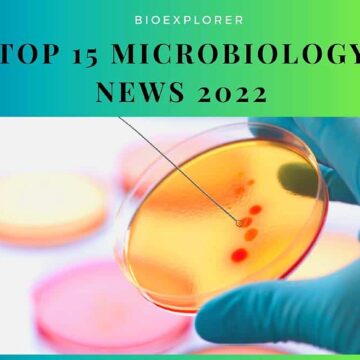

About BioExplorer.Net
Welcome to BioExplorer®, a comprehensive online resource dedicated to the fascinating world of nature and life around us. Initially established in 1999 as an aggregator of biology-related links, BioExplorer has since evolved into an extensive knowledge hub featuring over 1,500 in-depth articles.
We reach over 150,000 visitors monthly through the blog and social media. Our goal is to simplify science and make it easily consumable by everyone.
Jump to:
BioExplorer Recognitions/Media Mentions
#TV
Source: CBS News
# Printed Books
A Shot in the Arm: How Science, Engineering, and Supply
Cell Theory: The Structure and Function of Cells
Molecular Diagnostic PCR Handbook
Nuclear Waste Management (Science, Technology, and Policy)
Encyclopedia of Animal Behavior, Second Edition
Small Bite, Big Threat, Deadly Infections Transmitted by Aedes Mosquitoes
The Signature of God
High-Risk Pollutants in Wastewater
Biología y geología. Complementos de formación disciplinar
Islam dan Biologi
Economics, Ecology, and Policy for the Bioeconomy: A Holistic Approach
Effects of Electromagnetic Radiation on Living Beings
Brewery Safety Principles, Processes, and People
Edible Flowers, Health Benefits, Nutrition, Processing, and Applications
Encyclopedia of Animal Behavior: A-F
We have been quoted and referenced in many science journals (including NIH, News Medical & many Universities) and books. Here are some of the printed books referencing BioExplorer.net. Click the book images to see the reference.
# Look Who's Using BioExplorer
BioExplorer articles are cited daily by top magazines, online publishers, and many reputed universities worldwide.

Our Story
We are a dedicated team of biology enthusiasts worldwide who are passionate about this vast subject. We created this website because we all were fascinated by this wonderful phenomenon called "life" and wanted to share our love, curiosity, and never-ending yearning to learn more about the knowns and unknowns of this big, beautiful, and bright universe with the rest of the world.
Animals, plants, flowers, birds, book reviews, biology news, gardening, and everything around life on earth amuses us.

Ever since the onset of the pandemic, the world is more curious than ever to know how the field of science is evolving every day, and we at Bioexplorer.net have made it our priority to provide evidence-based information that our readers can rely on.
As the world is evolving at a faster pace, the importance of Biology and its scope in all walks of life is being felt more than ever now.
All articles that are published on the website are written by one of the many professionally qualified biology experts we have on our team. Each and every topic is well-researched and peer-reviewed before we can publish it on the blog to ensure accuracy and maintain the standard that we have created thus far, which is the reason that Bioexplorer.net has been quoted and referenced across the media, be it print or online, including many reputed and well-recognized educational institutions all around the world.
Our Team
Our team works passionately in shaping this website to be the best it can be by constantly evolving as we welcome more contributors to our family who bring new perspectives and increase the knowledge base. That said, we are always ears to hear from you, our followers, readers, and fellow biology nerds. So write away!
Thanks,
BioExplorer Team